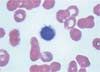

A 49-year-old man has had dyspnea on exertion for 1 month; it has worsened during the past 2 days. He has also had 2 episodes of epistaxis and increasing abdominal distention, without pain, during the past 6 months.
A 49-year-old man has had dyspnea on exertion for 1 month; it has worsened during the past 2 days. He has also had 2 episodes of epistaxis and increasing abdominal disten- tion, without pain, during the past 6 months. The patient has no history of recurrent infection or noticeable weight loss.

Figure 1
Figure 2
Blood pressure is 118/67 mm Hg; heart rate, 120 beats per minute; respiration rate, 34 breaths per minute; and temperature, 37.4°C (99.3°F). Skin and conjunctivae are pale without petechiae or purpura. The abdomen is protuberant. A CT scan of the abdomen reveals massive splenomegaly (Figure 1). There is no lymphadenopathy.
Hemoglobin level is 6 g/dL; hematocrit, 21%; mean corpuscular volume, 100.4 fL; and reticulocytes, 2.7%. White blood cell (WBC) count is 2400/µL, with 11% polymorphonuclear leukocytes, 61% lymphocytes, 6% atypical lymphocytes, and 22% monocytes; platelet count is 21,000/µL. Serum biochemical and coagulation profiles and liver function test results are normal.
A peripheral blood smear shows a hairy cell with abundant, irregularly distributed cytoplasm (Figure 2). Flow cytometry analysis of a bone marrow sample reveals CD11, CD19, CD20, and CD22. CD25, CD3, and CD5 are absent.
The patient is given cladribine (2-CdA), 0.1 mg/kg continuous infusion for 7 days, followed by epoetin alfa and filgrastim. Partial remission is achieved, and the splenic size decreases to 10.2 × 12 × 24 cm (original size, 26 × 15 × 35 cm). After another treatment with 2-CdA at the same dosage, a repeated WBC count is 3000/µL (with 10% polymorphonuclear leukocytes, 71% lymphocytes, and 19% monocytes), hemoglobin level is 14.7 g/dL, and platelet count is 110,000/µL. The cancer is currently in remission.
HAIRY CELL LEUKEMIA: AN OVERVIEW
This rare disease is characterized by prominent irregular cytoplasmic projections of the malignant B-lymphocyte cells.1 It occurs predominantly in men (male-to-female ratio is 4:1). The median age at onset is 52 years. Although the pathogenesis is unknown, Epstein-Barr virus infection and exposure to radiation and organic chemicals are considered predisposing factors.
CLINICAL MANIFESTATIONS
Hairy cell leukemia may present with cytopenia (anemia, neutropenia, thrombocytopenia, or pancytopenia in 60% to 85% of patients), splenomegaly, bleeding tendency, or infection. Massive splenomegaly may contribute to dyspnea and early satiety. (This patient's dyspnea was related to the massive splenomegaly and anemia.) About 25% of patients may be asymptomatic on presentation. Azotemia, abnormal liver function, and leukocytosis may be present in up to one third of patients.1,2
WORKUP
Consider splenic lymphoma with villous lymphocytes, chronic lymphocytic leukemia, and prolymphocytic leukemia in the differential diagnosis.

The characteristic hairy cells can be seen on peripheral blood smears of most patients with hairy cell leukemia, but the leukemic cells need not be hairy. Historically, demonstration of tartrate-resistant acid phosphatase activity on peripheral blood smears helps establish the diagnosis. In hairy cells, results of the peroxidase stain are negative and lysozyme activity is absent.
Flow cytometry analysis of a bone marrow biopsy is essential for definitive diagnosis. Immunophenotypingyields hairy cells that are positive for pan B-cell surface antigens CD19, CD20, CD22, and CD25. CD103 is a sensitive marker for hairy cell leukemia. CD5 is absent.2,3
MANAGEMENT
Treatment options include chemotherapy (with interferon alfa or purine analogs) and splenectomy. Blood product transfusion may be used as supportive therapy. Patients with an absolute neutrophil count of less than 1000/µL, a hemoglobin level of less than 11 g/dL, and a platelet count of less than 100,000/µL require chemotherapy. Chemotherapy can also be offered to patients with constitutional symptoms.
Splenectomy is reserved for patients with symptomatic splenomegaly (massive enlargement, pain, infarction, rupture); those with pancytopenia that persists despite chemotherapy; and symptomatic pregnant women, as a temporizing measure.1,2,4 The advent of newer therapeutic agents has markedly reduced the need for splenectomy.
PROGNOSIS
Before the introduction of the nucleoside analogs and interferon alfa, the median survival was 50 months. With the current therapy, 95% of patients survive 5 years and 80% are alive at 10 years.1,2